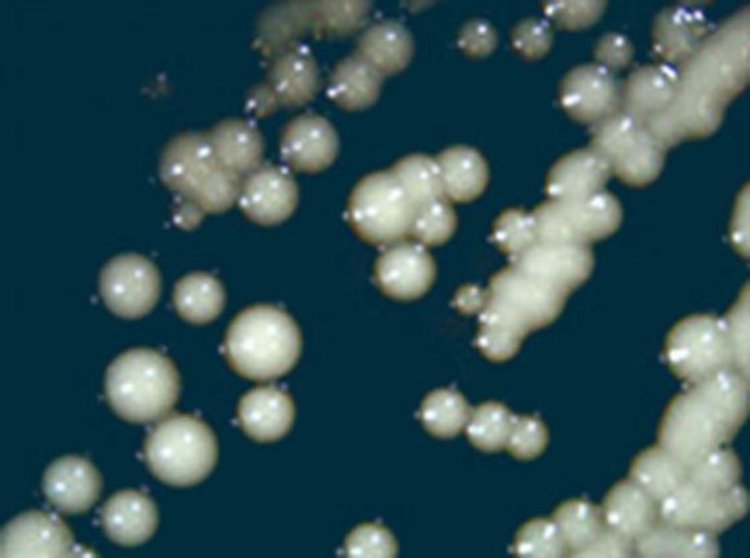
Щамът бирени дрожди EBEgT12, изолиран от съд в обекта Ен-Басор, Израел. Кредит: Aouizerat et al, doi: 10.1128/mBio.00388-19.

Мултидисциплинарен екип учени успешно изолира няколко щама дрожди от древни съдове, открити при археологически разкопки в Израел.
Изследователите успяват и да сварят "ароматна и вкусна" бира, използвайки древните щамове.
"Предполагахме, че порите на глинените съдове, в които са абсорбирани големи количества ферментационни дрожди са променили трайно микрофлората на съда," разказва водещият автор д-р Ронен Хазан (Dr. Ronen Hazan) от Еврейския университет в Йерусалим. "Наистина, тестването на няколко съвременни съда, пълни с филтрирана и нефилтрирана бира и заровени за три седмици под земята, както и тестове върху глинени съдове от вино, неизползвани повече от две години, доказаха, че дрождите могат да бъдат открити в глинените пори дори след дълго време."
Д-р Хазан и съавторите му търсят древни дрождеви клетки в съдове от пиво и подобна на медовина напитка от няколко археологически обекта.
"Изследвахме древните керамични съдове от три различни исторически периода, открити на четири различни места в Израел," обясняват учените. "Във всеки от тези обекти са открити съдове, за които се предполага, че са били свързани с ферементирали напитки"
Най-древните съдове са от два обекта от ранната Бронзова епоха (3100 пр.н.е.).
"Първият обект е Ен-Бесор в северозападната част на пустинята Негев, място, свързано с дейността на египтяните в Южен Ханаан в края на четвъртото хилядолетие пр.н.е. Вторият обект е наскоро открит на улица Ха-Масгер в Тел Авив и съдържа фрагменти от съдове, типични за египетските пивоварни, може би свидетелство за отделена територия измежду селищата на ханаанците," поясняват учените.
Третият обект е филистимското селище Тел ес-Сафи/Гат в Централен Израел.
"Филистимците, един от така наречените Морски народи са важна култура в района на Леванта (днешен Израел и Ливан) по време на Желязната епоха (1200 до 600 г. пр.н.е.) и често са споменавани в Библията като врагове на израилтяните. По онова време Гат е най-голямото и важно филистимско селище в региона", разказват авторите.
"Изследвахме 12 проби от две много добре запазени филистимски кани, които обикновено се свързват с бира или други ферментирали алкохолни напитки, заради чучура и цедката на стената им."
"Четвъртият обект е Рамат Рахел, разположен между Йерусалим и Витлеем. По времето на Желязната епоха и персийския период (ок. 8-ми до 4-ти век сл.н.е.), е служел за резиденция на местните представители на Асирийската, Вавилонската и Персийската империя, като център за събиране на данъци и за специфични празненства. От този обект изследвахме четири кани за съхранение, типични за региона на Юдея по времето на ранния персийски период."
Учените успяват да изолират шест щама дрожди от 21 древни съда, използвани за вино и медовина. След това секвенират целия геном на всеки щам и откриват, че дрождите са много подобни на тези, използвани в традиционните африкански напитки като етиопското медено вино "теж" и на съвременните бирени дрожди. Накрая учените изследват способността на изолираните дрожди да произвеждат алкохолни напитки, които да стават за пиене. Три от тях, от Ен-Бесор, Тел ес-Сафи/Гат и Рамат Рахел произвеждат ароматна и вкусна бира.
"Най-голямата изненада беше, че дрождевите колонии са оцелели в съдовете хиляди години, чакайки да бъдат открити", споделя д-р Хазан. "Древните дрожди ни помогнаха да създадем пиво, което ни показва каква е била на вкус бирата на древните филистимци и египтяни. А между другото, тя съвсем не е лоша. Освен вълнението, че пиеш бира от времето на фараоните, това изследване е особено важно за експерименталната археология - област, която опитва да възстанови миналото."
"Изследването ни предлага нови начини за изследване на древните методи и ни дава възможност да опитаме вкуса на миналото."
"Тук говорим за истински пробив," споделя съавтора д-р Ицхак Паз, от Израелската служба за антиките. "Това е първият път, когато успяхме да получим алкохол от древни дрожди. С други думи, от оригиналните съставки, от които се е получавал алкохолът. Това никога преди не е правено досега."
Изследването е публикувано в списанието mBio - Tzemach Aouizerat et al. 2019. Isolation and Characterization of Live Yeast Cells from Ancient Vessels as a Tool in Bio-Archaeology.
Източник: Sci news - Researchers Brew Beer with 5,000-Year-Old Yeasts